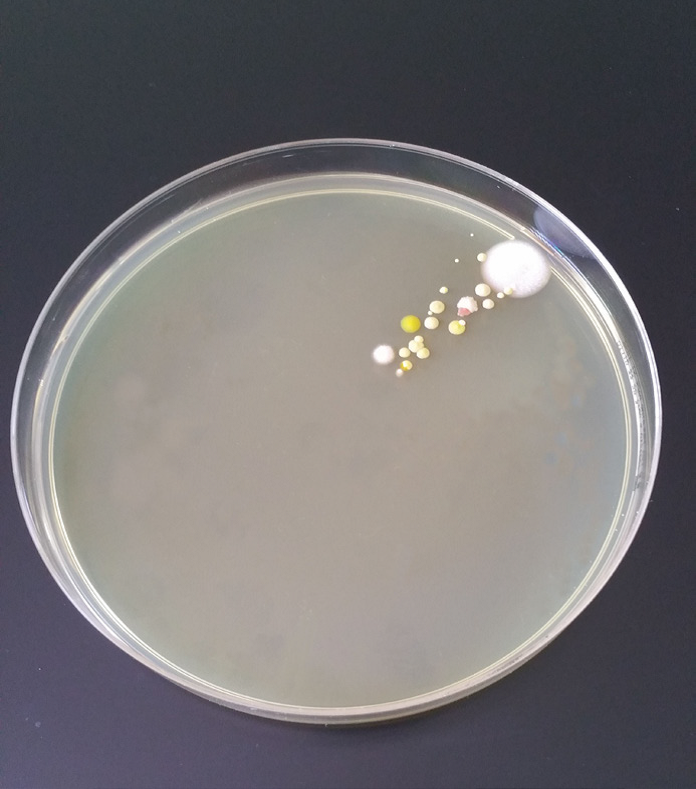

Product 1
project details Our laboratory is dedicated to cutting-edge research, advancing knowledge through meticulous experimentation. We bridge theory with Lorem Ipsum is simply dummy text of the printing and typesetting industry. practice, unlocking solutions to complex challenges. Together, we pioneer breakthroughs for a brighter future. Exploring biological systems for technological integration. Investigating microorganisms for health […]